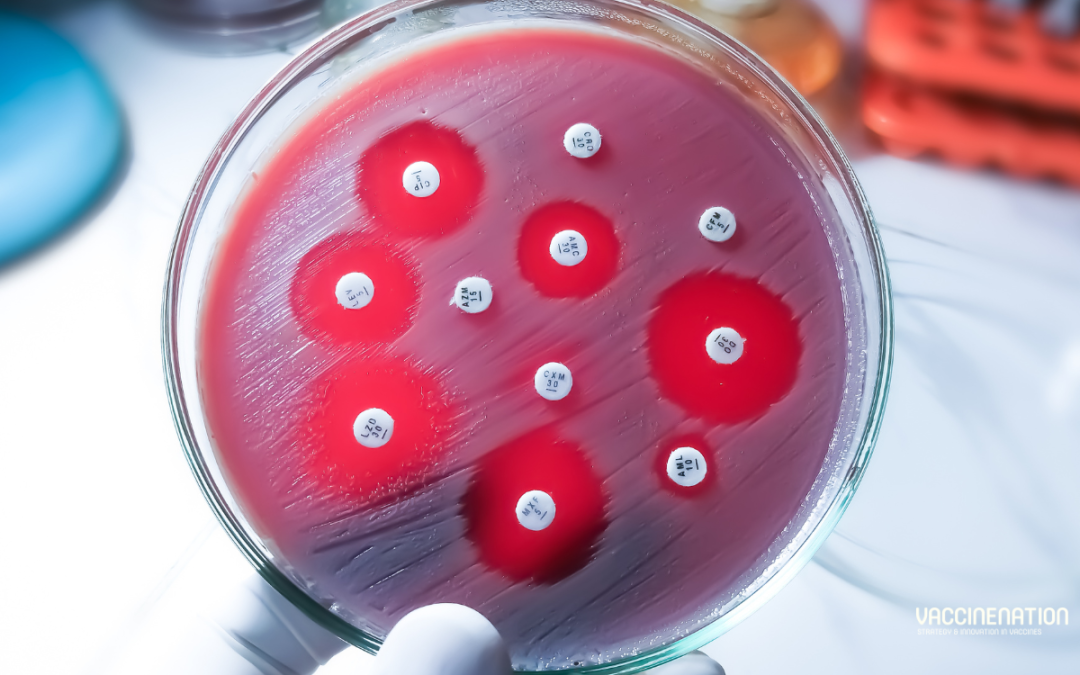
AMR report: vaccines could reduce antibiotics needed by 22%

by Charlotte Kilpatrick | Oct 24, 2024 | Global Health |
In October 2024 the International Finance Facility for Immunisation (IFFIm) priced a US$1 billion, 3-year fixed-rate bond to fund “critical vaccine research and immunisation programmes”. This is IFFIm’s largest single benchmark transaction in the primary market since its inaugural benchmark in 2006, with proceeds supporting Gavi and CEPI. The bond will mature on 29th October 2027 and carries a semi-annual coupon of 4.125% and a semi-annual re-offer yield of 4.222%.
“The success of this bond highlights the ongoing strength of IFFIm’s model, which leverages sovereign support and strong financial structuring to offer investment opportunities that make a positive impact on children’s health.”
The order book was IFFIm’s largest to date, exceeding US$4 billion. The bond drew interest from a diverse group of investors with geographic spread.
Support for vaccine programmes
IFFIm is an “important flexible tool” for organisations like Gavi; since 2006 it has provided Gavi with US$5.8 billion in financing, one sixth of its overall budget. It has been “critical” in enabling Gavi’s recent emergency responses as well as routine immunisation and health system resilience efforts. Dr Sania Nishtar, CEO of Gavi, reflected that IFFIm has been a “groundbreaking and indispensable tool”.
“Today’s bond issue provides us with vital flexibility in our mission to protect millions of children from preventable diseases and to protect our world from the threat of future pandemics.”
As Gavi nears the end of the 2021-2025 strategic period and prepares for the next phase, IFFIm states that the bond issue will play a “pivotal role” in supporting life-saving programmes.
IFFIm has also provided approximately US$272 million in past financing to CEPI in support of the research and development of new vaccines. Dr Richard Hatchett, CEO of CEPI, acknowledged the “serious threat to global health security” presented by epidemics and pandemics. He commented that these can be “mitigated through investment in vaccine R&D and manufacturing”.
“The IFFIm financing mechanism enables CEPI to access the critical funding it needs to accelerate the development of vaccines against emerging infectious disease threats, for the benefit of all.”
Offering opportunities
IFFIm Board Chair Ken Lay believes that the latest issue “highlights IFFIm’s unparalleled strengths”; it is “backed by sovereign donors, driven by a vital global mission, and structured to maximise impact”.
“IFFIm’s bonds continue to offer investors compelling opportunities to earn competitive returns with good secondary market liquidity and assured use of proceeds.”
Jorge Familiar, Vice President and Treasurer, World Bank commented that capital markets are a “powerful tool for connecting private investment with global public goods”.
“As IFFIm’s Treasury Manager, the World Bank is pleased to support IFFIm in accessing capital markets to provide a long-term and flexible funding source to Gavi to accelerate access to vaccines and vaccine development.”
Head of SSA and EMEA IG Syndicate, BofA Securities Adrien de Naurois congratulated the IFFIm team on a successful return to the USD market.
“Today’s transaction, the first USD benchmark in two years, is a clear demonstration of IFFIm’s loyal and diverse investor base, attracted by the importance of its mission to deliver immunisation programmes to those most vulnerable via the ongoing work of Gavi.”
For the latest vaccine news, don’t forget to subscribe to our weekly newsletters here.

by Charlotte Kilpatrick | Oct 23, 2024 | Global Health |
A study in The Lancet Global Health sought to provide counterfactual scenarios to evaluate the short-term effects of different vaccination strategies on mpox cases and deaths in the Democratic Republic of the Congo (DRC). The researchers used a dynamic transmission model to simulate mpox transmission, stratified by age and province; this was used to assess potential vaccination strategies and their effects on deaths and cases in an epidemic year. The results indicate that vaccinating children aged 15 years or younger, or younger than 5 years, in endemic regions, would be the “most efficient use of vaccines” when resources are limited.
Mpox in DRC
Mpox was first identified in the Democratic Republic of the Congo (DRC) in 1970; it is a zoonotic infectious disease caused by the monkeypox virus (MPXV), which is endemic in “numerous regions” of west and central Africa. MPXV has two clades:
- Clade I is endemic in central Africa with an estimated case fatality rate of up to 10% and mainly affecting children. It is divided into two subclades, Ia and Ib.
- Clade II was historically found in west Africa, with an estimated case fatality rate of up to 1%-3%. It is also divided into two subclades, IIa and IIb. Clade IIb was responsible for the global mpox epidemic in 2022.
The authors state that, until 2022, MPXV was not associated with large outbreaks; most cases were related directly to sylvatic transmission from animals to humans via hunting, wild game preparation, and consumption. Increases in human-to-human transmission were identified in 2017.
The researchers suggest that the low likelihood of transmission in the early decades after the virus’ discovery could be related to smallpox eradication programmes, which offered cross-immunity via vaccination against a related orthopoxvirus. Indeed, since the cessation of the smallpox vaccination programme in the DRC, there has been a “concurrent increase in mpox cases and outbreak frequency”. There is an ongoing, “unprecedentedly large” outbreak of clade I mpox in the DRC, with more than 14,000 reported suspected cases by the end of 2023 and a 4.6% case fatality rate. Over 70% of the deaths are in children younger than 15 years.
Genetic analyses of clade Ia MPXV genomes indicate that in this outbreak, multiple, independent zoonotic introductions into the human population have occurred from one or more reservoir species. An increasing burden of clade Ib MPXV infections have been identified in eastern DRC with evidence of “sustained” human-to-human transmission and many cases in women aged 15-29 years, but clade Ia infections continue to comprise most mpox cases in the DRC.
The study
Bavarian Nordic’s modified vaccinia Ankara vaccine (JYNNEOS) is protective against mpox. It was approved by the US FDA in 2019 but was not widely used against mpox until the 2022 outbreak, when it was “quickly mobilised to vaccinate people at high risk of infection in the USA and Europe”. Despite its high efficacy at two doses, it is “largely unavailable” outside the USA and Europe.
The authors aimed to inform policy and decision makers on the “potential benefits of, and resources needed,” for mpox vaccination campaigns in the DRC. They used an approach based on models from operations research and decision science to offer a robust analysis of policy choices “even in the context of incomplete and uncertain data”. The study uses mathematical modelling to simulate the spread of mpox in the DRC during 2023.
Without vaccination, the model predicted 14,700 cases of mpox and 700 deaths from mpox in the DRC over 365 days, consistent with reported estimates. Almost 50% of the cases and deaths came from the province of Equateur. Cases were evenly split between the three age groups: 34% in children under 5 years, 32% in children aged 5-15 years, and 34% in people older than 15 years. However, deaths were “predominantly” seen in children younger than 5 years (51%).
Vaccinating 80% of children younger than 5 years in all provinces or provinces with a history of mpox cases decreased the outbreak to 10,500 cases and 400 deaths. Vaccinating in endemic provinces increased cases to 10,700 and deaths remained the same. The numbers of vaccine doses needed for the strategies were 41.4 million (all provinces), 33.8 million (provinces with a history of mpox), and 13.2 million (endemic provinces only).
Vaccinating 80% of children younger than 15 years in all provinces or provinces with a history of mpox cases decreased the outbreak to 6,400 cases and 200 deaths. Vaccinating in endemic provinces increased cases to 6,800 and deaths remained the same. The numbers of vaccine doses required for these strategies were 81.6 million (all provinces), 67.1 million (provinces with a history of mpox), and 26.6 million (endemic provinces only).
Vaccinating 80% of all ages in all provinces or only non-endemic provinces with a history of cases decreased the case burden to 1,400 cases and 100 deaths, and 2,000 cases and 100 deaths when vaccinating in provinces endemic for mpox. The numbers of doses required for these strategies were 170.8 million (all provinces), 142.0 million (provinces with a history of mpox), and 56.8 million (endemic provinces only).
Managing resources
The paper finds that vaccinating all ages leads to the “largest impact on magnitude of cases and deaths”, but that vaccinating only children aged 15 years or younger provides “nearly the same effect with fewer vaccine doses required”. Although vaccinating only children younger than 5 years showed a “drop-off” in averted cases and deaths, it provides the most efficiency.
“This analysis shows the effectiveness of focussing an mpox vaccination campaign specifically in the provinces endemic for mpox in the DRC. This targeted strategy prevents nearly as many cases and deaths as broader approaches but uses fewer vaccine doses and thus would be less costly to implement.”
Alexandra Savinkina, fourth year PhD student in the Yale School of Public Health (YSPH) Department of Epidemiology (Microbial Diseases), commented that this study could influence vaccination policy.
“My hope is that it could help inform policy for vaccination in the country and potentially the region and move the needle forward on getting vaccines to the people who need them most in the DRC.”
Savinkina hopes that “we can learn from the global mpox outbreak that we can’t ignore disease in other places”.
“If the resources to help people exist, I think we should be using them, whether in the U.S. or in Africa.”
Dr Gregg Gonsalves, associate professor of epidemiology at YSPH, acknowledged barriers to access.
“We take it for granted that we can get a vaccination for COVID or a flu shot at our local CVS, but the infrastructure to deliver vaccines in DRC is far less robust.”
For more vaccine research updates, subscribe to our weekly newsletters here.

by Charlotte Kilpatrick | Oct 21, 2024 | Global Health |
In October 2024 WHO certified Egypt as malaria-free after a “nearly 100-year effort” by the government and people to end the disease. WHO described this as a “significant public health milestone” for the country’s more than 100 million inhabitants. Egypt is the third country to receive this certification in the WHO Eastern Mediterranean Region, following the United Arab Emirates and Morocco.
Across the globe, 44 countries and 1 territory have achieved this status by proving beyond reasonable doubt that the chain of indigenous malaria transmission by Anopheles mosquitoes has been interrupted nationwide for at least the previous three consecutive years. A country must also demonstrate its capacity to prevent the re-establishment of transmission.
Malaria becomes history
WHO states that malaria has been traced back as far as 4000 BCE in Egypt; there is genetic evidence of the disease in Tutankhamun and other ancient Egyptian mummies. More recently, efforts to reduce human-mosquito contact began in the 1920s with the prohibition of rice cultivation and agricultural crops near homes. With much of the population living along the banks of the Nile River and malaria prevalence “as high as 40%”, malaria was designated as a notifiable disease in 1930.
By 1942, malaria cases in Egypt exceeded 3 million due to population displacement caused by the Second World War, the disruption of medical supplies and services, and the invasion of Anopheles arabiensis, which is a “highly efficient mosquito vector”. Egypt responded to the outbreak by establishing 16 treatment divisions and recruiting more than 4000 health workers. The Aswan Dam, completed in 1969, brought an additional risk of malaria as standing water provides a mosquito breeding ground. Thus, Egypt worked with Sudan to launch a “rigorous” vector control and public health surveillance project.
By 2001, malaria was “firmly under control”, encouraging the Ministry of Health and Population to work on preventing the re-establishment of local malaria transmission. Egypt “rapidly” contained a small outbreak in the Aswan Governorate in 2014. The recent certification recognises continued efforts and initiatives including the free provision of malaria diagnosis and treatment to the population, regardless of legal status, and health professionals’ training to detect and screen for malaria. The country also has “strong” cross-border partnerships with neighbours like Sudan, which have been “instrumental”.
The beginning of a new phase
Dr Tedros Adhanom Ghebreyesus, WHO Director-General, congratulated Egypt on its achievement.
“Malaria is as old as Egyptian civilisation itself, but the disease that plagued pharaohs now belongs to its history and not its future. This certification of Egypt as malaria-free is truly historic, and a testament to the commitment of the people and government of Egypt to rid themselves of this ancient scourge.”
Dr Tedros hopes that this will be an “inspiration to other countries in the region”, showing “what’s possible with the right resources and the right tools”. Deputy Prime Minister of Egypt H.E. Dr Khaled Abdel Ghaffar commented that the certification is “not the end of the journey but the beginning of a new phase”.
“We must now work tirelessly and vigilantly to sustain our achievement through maintaining the highest standard for surveillance, diagnosis and treatment, integrated vector management, and sustaining our effective and rapid response to imported cases. Our continued multisectoral efforts will be critical to preserving Egypt’s malaria-free status.”
Dr Abdel Ghaffar reaffirmed that the country will “continue with determination and strong will”. WHO Regional Director for the Eastern Mediterranean Dr Hanan Balkhy emphasised that the success is “not just a victory for public health but a sign of hope for the entire world”, including other endemic countries in the region.
“This achievement is the result of sustained, robust surveillance investments in a strong, integrated health system, where community engagement and partnerships have enabled progress. Furthermore, collaboration and support to endemic countries, such as Sudan, remain a priority.”
For insights into the latest malaria vaccine development progress, join us at the Congress in Barcelona next week. Don’t forget to subscribe to our weekly newsletters here.

by Charlotte Kilpatrick | Oct 18, 2024 | Global Health |
The Global Polio Eradication Initiative (GPEI) announced the “difficult decision” to extend the timelines needed to achieve polio eradication. This decision, made by the Polio Oversight Board (POB) in July 2024, was shared in October 2024 with an update to funding requirements. Although GPEI recognised the “unprecedented progress” made so far, it highlighted the danger of falling into an “unacceptable future”, demanding collaboration and support for the next stages of eradication efforts.
Progress against polio
GPEI commented that “for more than three and a half decades” it has been supporting governments and health workers to make “unprecedented progress toward the promise of a polio-free world”. Through this work, more than 20 million people are “walking who would otherwise have been paralysed by this dreadful disease”. “Billions” of children have benefitted from lifesaving immunisations, and five out of six WHO Regions are free from wild poliovirus.
Closing the gaps
With broad global success, the programme is largely now “concentrated in some of the most complicated and fragile settings in which to deliver basic healthcare”. It faces “serious”, from “persistent violence to climate emergencies”. Indeed, the transmission of polio in conflict-affected areas in Gaza, Sudan, and Yemen, provides a “stark reminder” that “where conflict debilitates health and sanitation systems, polio will inevitably appear” unless eradication of all forms of the virus can be achieved.
Extended timelines
In recognition of the continued challenges, the GPEI’s POB decided to extend the timelines needed to achieve polio eradication to the end of 2027 (wild poliovirus) and the end of 2029 (type 2 variant poliovirus). The decision, made in July 2024, was informed by “critical analysis and expert consultations”. The consequence of this extension is a need for further financial resources.
In October 2024, the POB determined that the total funding needs of the extended 2022-2029 strategic period are US$6.9 billion; this is an increase from the US$4.8 billion projected for the 2022-2026 strategic period. Donors have already committed an “incredible” US$4.5 billion, leaving US$2.4 billion “urgently needed”. The funds will enable the programme to make “tactical shifts”, allowing GPEI to:
- Reach more children with polio vaccines by working with polio-affected country leaders to strengthen programme implementation
- Deploy innovative tools like novel vaccines and surveillance methods to further strengthen outbreak response
- Improve accountability at all levels, from global leadership to field managers
- Work with routine immunisation programmes by integrating polio services where possible
- Deepen relationships by strengthening community engagement
These “shifts” are driven by partners’ expertise and a “programme-wide commitment to double down on the toughest but most critical challenges”.
GPEI warns that shortcomings in funding or executing these efforts would have “serious consequences”.
“Without dedicated eradication efforts, within a decade, many thousands of children around the world could once again be paralysed or die from polio each year. This is an unacceptable future.”
The importance of donor and polio-affected country governments supported is highlighted as central in reaching all children with lifesaving vaccines and strengthening health systems in the process.
“With strengthened support and collaboration, together we can deliver a world where all children, families, and communities are forever free from polio.”
For the latest vaccine and global health updates, don’t forget to subscribe to our weekly newsletters here.

by Charlotte Kilpatrick | Oct 17, 2024 | Global Health |
A study in The Lancet Global Health estimates the impact that the 100 Days Mission could have had on the COVID-19 pandemic. The authors find that the implementation of non-pharmaceutical interventions (NPIs) within the 100 Days Mission could have averted around 8.33 million deaths, corresponding to a monetary saving of US$14.35 trillion. Investment in manufacturing and health systems contribute an increase to 11.01 million deaths averted. The researchers comment on the value of the 100 Days Mission but emphasise the importance of “prioritising a more equitable global vaccine distribution”.
In search of greater vaccine benefits
Although COVID-19 vaccines are estimated to have prevented almost 20 million deaths, the authors demand a better understanding of the “further health and economic benefits that could have been achieved” through shorter development times and “improved global equity in pandemic preparedness”. CEPI’s 100 Days Mission was proposed in 2021, establishing the ambition of cutting vaccine development time for new pathogens to 100 days. This about a third of the time taken to deliver the first COVID-19 vaccine.
“The availability of COVID-19 vaccines within 100 days would have substantially changed the pandemic; however, these benefits would be finite without enabling equitable access to vaccine products through system equity.”
Various efforts to encourage global vaccine distribution were “hampered” by inequities, and it is recognised that manufacturing capacity should be “expanded but also diversified” to “promote self-sufficiency and regional resilience”. Furthermore, supply chains and infrastructure must be scaled to enable the delivery of vaccines that rely on cold-chain infrastructure.
The study
The searchers hoped to quantify the potential impact of the 100 Days Mission by retrospectively estimating the effect it would have had on the COVID-19 pandemic, thus offering evidence to support decision making around future investments in research and development capabilities. They also aimed to quantify the impact of “additional investments”.
The analyses use an extended version of a previously published compartmental susceptible-exposed-infectious-recovered transmission model of COVID-19 vaccination with an explicit healthcare pathway. The vaccination pathway was expanded to include booster vaccination alongside waning efficacy, capturing the “restoration of immunity” through booster doses. The new vaccination pathway was parameterised to match platform-specific vaccine efficacy data and the duration of protection.
The authors modelled the impact of the 100 Days Mission by simulating a counterfactual scenario where the global vaccination campaign began on 20th April 2020, 100 days after the publication of the full SARS-CoV-2 genome. This scenario assumes that vaccinations in each country took the same roll-out process, but 232 days earlier. Two additional scenarios reflected “increased investment” in research and delivery infrastructure.
The Manufacturing scenario removed supply constraints, enabling the rollout of vaccination on 20th April 2020 in every country, without stockouts. The infrastructure-equity scenario enhanced both national health systems and global distribution networks so that all countries achieved 40% vaccine coverage in the first year and 40% booster coverage in the second year.
To account for the relaxing of non-pharmaceutical interventions (NPIs), the authors simulated three scenarios for NPI relaxation speeds as vaccination coverage improved. The History scenario assumed no changes, whereas the Target and Economic scenarios assumed earlier relaxing; the Target scenario lifted all restrictions over two months after reaching more than 80% adult coverage in high-income countries or more than 80% coverage in those older than 60 in other countries. The Economic scenario lifted NPIs more gradually after reaching the over-60 target, prioritising the reopening of schools.
Study findings
The results suggest that the 100 Days Mission could have averted an additional 8.33 million deaths due to COVID-19 by the end of 2021 when combined with the History NPI lifting scenario. In this scenario, an estimated 26.72 million severe cases of COVID-19 requiring hospitalisation and 1/44 billion infections would have been averted. Most of these averted deaths, hospitalisations, and infections would have occurred in low- and middle-income countries (LMICs).
The estimated VSLs (value of a statistical life) that could have been saved by the 100 Days Mission through the History scenario is US$22.61 trillion globally. As VSLs are “significantly higher” in HICs, 57% of the global value of statistical life averted occurred in HICs, even though most deaths would have been averted in LMICs. To estimate the monetary values associated with lives saved the authors multiplied the number of lives saved by the country-specific monetary VSL and by the value of a statistical life-year (VSLY).
“Increased investment in both global manufacturing and health systems infrastructure further increases the number of deaths that could be averted and the associated health-economic savings.”
In the 100 Days Mission with both manufacturing and health systems investments, an estimated 11.01 million deaths could have been averted and a value of $31.29 trillion in statistical lives saved. However, the authors describe this scenario as “unlikely”. In all scenarios involving the relaxing of NPIs thanks to earlier availability of vaccines, additional lives would have been saved.
In the Target NPI lifting scenario, an estimated 5.76 million deaths (100 Days Mission alone) to 9.20 million deaths (100 Days Mission with both manufacturing and infrastructure investments) could have been averted. In these scenarios, 12,600 and 23,900 fewer days of NPIs would have been implemented globally: 70 days and 133 days on average per country. Under the Economic scenario there were “similar trade-offs between public health and economic gains”. The public health and health economic outcomes would be greater than under the Target scenario, but still lower than the History scenarios.
Substantial benefits
“Earlier access to COVID-19 vaccines could have had substantial benefits.”
Most of the estimated averted deaths would have been concentrated in LMICs, but this demands investments in vaccine research, supported by “improvements to manufacturing and health system infrastructures”. With these investments, the authors estimate that 11 million deaths could have been prevented globally.
Although NPIs were effective at reducing transmission they incurred “significant economic and societal costs”, including consequences for education. Therefore, a major benefit of earlier access to vaccination is the reduction in school closures; in the Economic scenario, prioritising school opening could have averted 1,120 weeks of full school closures and 2,490 of partial school closures. This represents an average of 6 weeks of fully open schools and 14 weeks of partly open schools per country.
“Reopening schools and relaxing NPIs safely will crucially require scaling up both vaccine delivery infrastructure and manufacturing. Without addressing both aspects, advancements in vaccine development speed might not translate into equitable benefits globally.”
The results emphasise the importance of investments in support of the 100 Days Mission in controlling a future potential pandemic, with benefits for both health and economy.
“The 100 Days Mission is ambitious, requiring global innovation through creating vaccine libraries, clinical trial networks, accelerated immune response marker identification, rapid vaccine manufacturing, and strengthened global disease surveillance.”
CEO of CEPI, Dr Richard Hatchett, hopes that this research will encourage global commitment to the 100 Days Mission.
“This work shows in the starkest terms why the world needs to be prepared to move faster and more equitably when novel pandemic disease threats emerge. Investing in preparedness now to make the 100 Days Mission possible for future incipient pandemics will save millions upon millions of lives and protect the global economy against catastrophic losses.”
Join us at the Congress in Barcelona this month to explore how lessons from the COVID-19 pandemic can inform better global preparedness for pandemic and epidemic pressures, and don’t forget to subscribe to our weekly newsletters here.

by Charlotte Kilpatrick | Oct 16, 2024 | Global Health |
In October 2024, parliamentarians from across the world met at the UNITE Global Summit in Berlin to sign a statement in support of the WHO Pandemic Agreement. The statement was described by WHO as a “significant commitment” to “strengthen pandemic preparedness, response, and equitable access to health”. The Summit was held in collaboration with the World Health Summit (WHS), drawing global parliamentarians, civil society leaders, and health experts to “translate discussions into actionable policy priorities”.
Building trust for a healthier world
The World Health Summit 2024 was held under the theme “building trust for a healthier world”, focussing on inspiring “innovative solutions for better health and well-being for all”. The UNITE Global Summit agenda reflected key topics highlighted during WHS, divided into four pillars:
- Human rights and equitable access to health
- Global health architecture and security
- Strengthening of healthcare systems
- Sustainable financing for health
Support for the Pandemic Agreement
The Pandemic Agreement is under negotiation by WHO Member States as an attempt to address the “gaps” exposed by the COVID-19 pandemic and the threats presented by mpox and other disease outbreaks. It also seeks to “strengthen global collaboration pandemic prevention, preparedness, and response”.
A critical moment during the summit was the signing of the Global Parliamentary Statement in Support of the Pandemic Agreement, which demonstrated the importance of parliamentarians in “ensuring global health security and safeguarding populations against future pandemics”. The statement emphasised their commitment to ensuring that “all countries, regardless of resources, have access to the tools, capacities, resources, and healthcare required” during a pandemic.
Dr Ricardo Baptista Leite, President of UNITE, commented that parliamentarians are the “voice of the people” and carry a “crucial responsibility in safeguarding public health”.
“The WHO Pandemic Agreement represents a historic opportunity to prevent pandemics and strengthen our global preparedness and response capabilities. By signing this statement, we are not only showing our support for the agreement but also pledging to ensure that its principles of equity, solidarity, and global cooperation are fully realised in every nation.”
WHO Director-General Dr Tedros Adhanom Ghebreyesus welcomed the support for the “once-in-a-generation opportunity to build a stronger, fairer, and more prepared global health system”.
“By signing this statement, parliamentarians from around the world are showing their commitment to protecting lives from future pandemics and ensuring equitable access to vaccines, treatments, diagnostics, and other health tools for every country, particularly those with fewer resources.”
Key commitments
The Global Parliamentary Statement emphasises four “key commitments”:
- Equity at the core – ensuring equitable access to pandemic-related health tools based on public health need for everyone, especially countries with fewer resources
- Global solidarity – strengthening international cooperation to build resilient health systems that can prevent and respond to pandemics
- Legislative action – advocating for the ratification and implementation of the Pandemic Agreement within national legislatures, as appropriate
- Combating misinformation – providing communities with evidence-based health information to counter the spread of harmful misinformation
Dr Baptista Leite reflected that “the challenges we face today demand a global response”.
“No single country can prevent or combat pandemics alone. The WHO Pandemic Agreement is an essential step forward in ensuring that every nation has the tools, resources, and capabilities to respond to future health threats.”
More work to be done
WHO states that the Pandemic Agreement “needs to continue to garner broad international support”. Within the latest commitment, parliamentarians are to work with WHO and other international organisations to ensure the Pandemic Agreement is implemented in a way that “benefits all countries”, particularly those with “limited resources”.
“The statement signed in Berlin is expected to act as a catalyst for global parliamentary action, fostering collaboration and solidarity among nations.”
Join us at the Congress in Barcelona this month for a keynote discussion on “strengthening global preparedness and building resilient health systems” with experts from the field, and don’t forget to subscribe to our weekly newsletters here.

by Charlotte Kilpatrick | Oct 15, 2024 | Global Health |
A study in Emerging Infectious Diseases explores the association between COVID-19 vaccination and facial palsy (FP) in South Korea. The authors use an immunisation registry linked to the national health information database to compare FP incidence in a risk window with a control window. They found an increased FP risk within 28 postvaccination, primarily after first and second doses of both mRNA and viral vaccines. They encourage clinicians to “carefully assess” the FP risk-benefit profile associated with COVID-19 vaccines and monitor neurologic signs after vaccination.
Risk of facial palsy
Although no severe safety concerns were observed during the clinical trials of COVID-19 vaccines, an “imbalance” in facial palsy (FP) incidence after vaccination was identified in vaccinated persons compared to the general population. The aetiology of FP “remains elusive”, but autoimmune mechanisms or vaccination are “considered potential contributors to its development”. FP is included in the priority list of adverse events of special interest generated by the Safety Platform for Emergency vACcines (SPEAC) because of its “sudden and acute symptom onset”.
Despite multiple studies on the association of FP with COVID-19, we lack a “clear consensus”. As these studies have produced “controversial and inconclusive results”, the authors identified a need to generate an “in-depth body of evidence and a clear consensus” on the subject.
The study
The study uses two large, linked databases in South Korea to conduct a self-controlled case series analysis. It is intended to provide evidence on the safety of COVID-19 vaccines for immunisation under the COVID-19 Vaccine Safety Research Committee (CoVaSC) in South Korea. Several vaccines were available during the study period in South Korea:
- BNT162b2 (Pfizer-BioNTech)
- mRNA-1273 (Moderna)
- ChAdOx1 nCoV-19 (AstraZeneca)
- Ad.26.COV2.S (Janssen)
- NVX-CoV2373 (Novavax)
The researchers identified persons aged 18 and older who received an initial COVID-19 vaccine dose between 26th February 2021 and 1st March 2022. Among this population, they identified and included patients with a primary FP diagnosis accompanied by a prescription for corticosteroids between 26th February 2021 and 31st October 2022; patients who had received a COVID-19 vaccination and had incident FP diagnosed within a prespecified observation period were also included.
Exclusion criteria included foreign born residents, participants in clinical trials, persons vaccinated abroad, and persons deviating from vaccination guidelines to account for potential exposure misclassification. Persons with a history of FP in the year preceding the observation period and those whose FP cases occurred after the end of the observation period were excluded.
44,564,345 persons in South Korea were administered 129,956,027 COVID-19 vaccines doses between 26th February 2021 and 1st March 2022. During the study period, 15,472 FP cases with corticosteroid prescriptions were identified. Among these, 5,211 occurred up to 28 days postvaccination: 4.0 GP cases/1 million doses. Among the FP study population, the mean age at first COVID-19 vaccination was 53.1 years. 54.7% were male and 45.3% were female.
The study showed FP risk increased within 1-28 days after any COVID-19 vaccine dose. Increased FP risks were observed with the second dose and combined first and second doses, but no association was found for the third dose. The increased FP risk was identified across vaccine types. The incidence rate ratios (IRR) were “generally consistent” across age groups and, after application of the Benjamini-Hochberg adjustment, “generally remained consistent” across sex.
Implications
The findings of this study add to growing evidence of a positive association between FP and COVID-19 vaccination. The exact biological mechanism for the development of FP after vaccination remains unknown. However, “plausible links” between FP and mRNA and viral vector vaccines have been proposed. The study revealed increased FP risk in persons homologously vaccinated with mRNA vaccines, especially for BNT162b2 and in those with at least a single dose of mRNA vaccine. Furthermore, it revealed elevated risks among patients who received homologous dosing of viral vector vaccines.
An important consideration is the suggested link between COVID-19 infection itself and FP onset. In South Korea, the annual incidence of Bell’s palsy increased from 23.0 to 30.8 cases per 100,000 persons from 2008 and 2018. It reached 32.5 cases per 100,000 persons during 2021-2022, which suggests an increasing trend during the pandemic. Additionally, a study in South Korea indicated that COVID-19 infection is associated with a higher risk for Bell’s palsy for both COVID-19 vaccine recipients and nonrecipients.
“In conclusion, our study revealed a transient risk for FP after any dose of COVID-19 vaccine.”
The authors note that, although the risk for FP “appears elevated”, the absolute number of cases was “small”. Risk for FP should therefore not discourage patients from receiving COVID-19 vaccinations.
“Because FP is generally mild and manageable, physicians should monitor neurologic signs after COVID-19 vaccination and provide patients with a comprehensive evaluation of the risk-benefit profile associated with COVID-19 vaccines.”
Join us at the Congress in Barcelona this month to explore the processes by which vaccine safety is evaluated and monitored after rollout, and don’t forget to subscribe to our weekly newsletters here.

by Charlotte Kilpatrick | Oct 14, 2024 | Global Health |
Phase II trials of a “promising” human vaccine candidate against Rift Valley fever are beginning in Kenya with CEPI support. CEPI reported in October 2024 that this is the “most advanced stage of testing” for a human Rift Valley fever vaccine in an “outbreak-prone area”. Scientists at the University of Oxford and the Kenya Medical Research Institute (KEMRI)-Wellcome Trust Research Programme are leading the trial with $3.7 million funding from CEPI.
Rift Valley fever
First identified in Kenya’s Rift Valley, Rift Valley fever is usually found in people after direct contact with infected animals or bites from infected mosquitoes. Most infected people experience “mild disease”, but a small proportion develop the “severe haemorrhagic form”, with a risk of blindness, convulsions, encephalitis, and bleeding. In these cases, mortality rates can reach 50%.
Rift Valley fever has been detected across “much of Africa” and in the Middle East. It is mosquito-borne, which makes it “climate sensitive”. There is therefore a risk of outbreaks spreading to new areas or increasing in frequency or size. There are Rift Valley fever vaccines for animals, but no currently available or licensed vaccines for human use; the disease is a priority disease for R&D for WHO and CEPI.
ChAdOx1 RVF in trial
The vaccine, known as ChAdOx1 RVF, is based on the University of Oxford’s ChAdOx1 vaccine platform. It has shown positive results in healthy adults in the UK, meeting “many of the optimal product characteristics” of a WHO target product profile. It is one of three Rift Valley fever candidates in CEPI’s portfolio. 240 healthy adults will participate in the research, following local trial approvals.
Funding for the trial comes under CEPI’s strategic partnership with the University to accelerate the development of globally accessible vaccines against outbreak pathogens. Both organisations are “committed to enabling access to any vaccine outputs developed through this partnership”, including developing a target product profile suitable for low- and middle-income countries (LMICs), assessing the need for technology transfer, and priority supply to LMICs at an affordable price.
Professor George Warimwe, Principal Investigator of the trail and Deputy Executive Director of the KEMRI-Wellcome Trust Research programme, reflected that “nearly 100 years” after the disease was identified, there are “still no approved vaccines or treatments”.
“This vaccine trial brings us closer to addressing the rising frequency of outbreaks.”
Dr Richard Hatchett, CEO of CEPI, commented that Rift Valley fever “disproportionately affects the lives and livelihoods of vulnerable pastoral communities”, causing human fatalities and livestock losses.
“Investing in the promising human ChAdOx1 RVF vaccine diversifies CEPI’s portfolio and gives us a greater chance at protecting vulnerable populations against this worrisome threat that may become more prevalent with climate change.”
Director General of Africa CDC, H.E. Dr Jean Kaseya, agreed that the disease “leads to livestock losses and human fatalities, thus impoverishing communities who largely depend on livestock for their livelihood”.
“The launch of a Phase II clinical trial of a Rift Valley fever vaccine candidate in an endemic country is a crucial milestone in our efforts to control this disease. Africa CDC is proud to support this initiative that not only prioritises the health of our people but also demonstrates the continent’s growing leadership in advancing clinical research.”
Dr Kaseya stated that the ChAdOx1 RVF vaccine “offers hope to vulnerable populations” who are “disproportionately affected by the growing impact of climate change”.
Join us at the Congress in Barcelona later this month to explore efforts to address the growing challenges of climate change and infectious disease with vaccine development and don’t forget to subscribe to our weekly newsletters here.

by Charlotte Kilpatrick | Oct 14, 2024 | Global Health |
In October 2024 the European Investment Bank (EIB Global) announced €2 million financing for early-stage vaccine development in Rwanda by Akagera Medicines Africa Limited. The support is intended to accelerate research, development, and manufacturing of new vaccines against infectious diseases like tuberculosis, HIV, Lassa fever, and Ebola. It will also be used to “strengthen technical skills and expertise” to support “home-grown discovery, manufacturing, and development of vaccine delivery systems” in Rwanda.
Global Gateway
This financing is part of the EU Global Gateway initiative, a strategy to “boost smart, clean, and secure links in digital, energy, and transport sectors and to strengthen health, education, and research systems”. Team Europe is mobilising up to €300 million between 2021 and 2027 to “allow EU’s partners to develop their societies and economies” whilst creating opportunities for EU Member States to “invest and remain competitive”. EIB Global supports “high impact investment” to enhance healthcare and pharmaceutical manufacturing, encourage greater “health resilience”, and support equitable access to healthcare.
Continent-based solutions
EIB Global states that Africa bears the highest disease burden globally, demanding “more home-grown or continent-based solutions”.
“Vaccination is a critical activity to ensure and guide investments in universal health and has a crucial role to play in achieving 14 of the 17 United Nations Sustainable Development Goals.”
Akagera Medicines was founded in 2018 and registered a 100%-owned subsidiary in Kigali in 2022. Its mission is “targeting tuberculosis and other infectious diseases with liposomal nanotherapeutics”. Commenting on the financing announcement at the World Health Summit in Berlin, Chief Executive Officer Michael Fairbanks recognised the “significant support” of the European Investment Bank.
“We are now a clinical company and moving faster to build human capacity and specialised infrastructure in Africa to support vaccine development.”
CEO of the Rwanda Social Security Board (RSSB) Regis Rugemanshuro stated that the financial support is an “important contribution to the realisation of Rwanda’s vision to become a biotech hub” and the wider vision of “Africa becoming self-reliant in vaccine and medicine manufacturing”.
“RSSB is looking forward to deepening partnerships with EIB and other international institutions to build resilient healthcare ecosystems in Rwanda and in Africa.”
Vice President of EIB Thomas Ostros identified the Bank’s “close cooperation with public and private partners” to “accelerate development of innovative solutions”.
“The EIB is committed to further strengthening our partnership with local and international players, to scale up investment and support innovative technology together.”
Belen Calvo Uyarra, EU Ambassador to Rwanda, agreed that the investment was another “important milestone”.
“Through Global Gateway, the EU is focussed on advancing equitable access to health products and local manufacturing in Africa.”
For more from key players in efforts to establish local manufacturing capacities in Africa and champions of equitable access to health products, join us at the Congress in Barcelona later this month. Don’t forget to subscribe to our weekly newsletters here.

by Charlotte Kilpatrick | Oct 11, 2024 | Global Health |
A study in The Lancet in October 2024 finds that a single dose of typhoid conjugate vaccine (TCV) offers safe and effective protection against typhoid two years after vaccination in all children and sustained protection for older children at three to five years after vaccination. However, a “decline” in protection was observed after this period, with the greatest decline identified in children vaccinated at younger ages. The authors infer that a booster dose of TCV, perhaps around school entry age, might be needed for children vaccinated while younger than two years old, to sustain protection through the years when the risk is highest.
TCV
Typhoid fever places a “substantial disease burden” on low- and middle-income countries “marked by inadequate sanitation and limited access to clean water”. There are an estimated 7.15 million cases and 93,300 deaths each year. This burden is exacerbated by the “escalation” of antimicrobial resistance (AMR), which reduces treatment options. WHO recommends vaccines as an “important tool” in typhoid prevention and control strategies.
The first typhoid conjugate vaccine (TCV) was prequalified by WHO in 2017 based on field safety and immunogenicity data and findings from a controlled human infection model. 2-year vaccine efficacy has since been confirmed at 79-85% in randomised control trials. Research has revealed a “consistent trend” of waning protection in children vaccinated at a young age. Although WHO’s current recommendation is a single dose for infants and children from 6 months of age, epidemiological studies in countries across Asia and Africa suggest that incidence peaks in children between the ages of 5 and 9 years. Therefore, the authors identified a need to understand if a single dose of TCV can provide “substantial protection” in the medium and long term, or if a booster dose is needed.
Expanding the TyVAC trial: TyVOID
The cluster-randomise controlled trial (TyVAC) to assess the safety, immunogenicity, and protection conferred by a single dose of TCV started in Bangladesh in 2018 with a follow-up to 18 months. To generate further data, the authors extended this to evaluate vaccine protection and immunogenicity at 3-5 years after vaccination.
In TyVAC, healthy children aged 9 months to 15 years were offered TCV or a Japanese encephalitis vaccine according to their cluster of randomisation. 150 clusters were randomised to either TCV or the Japanese encephalitis vaccine, with 75 in each group. After a 3-month passive surveillance period, the baseline of TyVOID began at the final visit of TyVAC. Vaccinated children visited study clinics; after unmasking, participants in the Japanese encephalitis group were offered vaccination with a single dose of TCV, but TCV recipients were not offered the Japanese encephalitis vaccine.
Two cohorts of TCV-vaccinated children were available for follow-up:
- The group vaccinated in the original study between April 2018 and November 2019 (previous-TCV group)
- The group originally vaccinated with Japanese encephalitis and later TCV between January and August 2021 (recent-TCV group)
Results
During a median of 2.4 years, 14 episodes of typhoid fever were detected in the recent-TCV group (incidence rates of 31 per 100,000) and 45 episodes among the previous-TCV group (incidence rates of 97 per 100,000). The “significantly higher” incidence of typhoid fever in the previous-TCV group indicates a “drop in the vaccine effectiveness” 3-5 years after vaccination. The waning of vaccine effectiveness was further confirmed through the inclusion of unvaccinated children who sought care for fever as the reference group.
The decline in vaccine effectiveness correlated with age at vaccination; children in the youngest age group exhibited the most substantial reduction in vaccine effectiveness. The reason for the age-specific difference is “unclear”, but the authors suggest that underdeveloped bone marrow in younger children results in a weaker ability to support long-lived plasma cells. Another possibility is that older children have more opportunities for exposure to S Typhi than younger children, contributing to a greater durability of antibody concentrations after vaccination.
The issue of exposure is also relevant in comparing this study to a study in Malawi, as the incidence of typhoid fever in Bangladesh was “approximately three times higher”, with greatest disparity in younger children. Therefore, while a single dose of TCV might remain “highly effective” in Malawian children, it ceases to confer sufficient protection in Bangladeshi children.
“Put simply, it may be that more antibody is needed in Bangladesh to protect against typhoid fever than in Malawi as the incidence of infection is likely to be higher in Bangladesh.”
Implications
The introduction of TCV as a catch-up campaign in several countries is “likely to have a substantial impact” on the typhoid burden in these countries. TCV will then be integrated into local EPI programmes with a single dose, focussing on infants and toddlers. However, the authors urge WHO to evaluate their data and consider the “potential need for a booster around school entry age”.
Associate Professor Xinxue Liu of the Oxford Vaccine Group is one of the senior authors and emphasised how “serious and life-threatening” the disease is, particularly for “children and adolescents in low- and middle-income countries”.
“TCV offers the best chance to reduce the burden of typhoid, helping to reduce transmission and limiting further evolution of drug-resistant strains. This study provides additional information for policy makers on longer-term TCV protection and the importance of continued investigation and updated guidance.”
Dr Firdausi Qadri, Senior Scientist at the Infectious Diseases Division at the International Centre for Diarrhoeal Disease Research, Bangladesh (icddr,b) and first author, commented that the results “indicate a decay in antibody concentrations in different age groups”.
“[They] suggest that a booster dose around school entry age for children vaccinated while younger than 2 years could be considered, to sustain the protection from TCV through the school years when children are at greatest risk of typhoid.”
Professor Sir Andrew Pollard, Director of the Oxford Vaccine Group, reflected on WHO’s “current” recommendation.
“Epidemiological studies in different countries across Asia and Africa showed that the incidence of typhoid fever is much higher in children younger than 16 years than it is in adults, with the peak of cases seen in those aged 5-9 years. Whether a single dose of TCV provides long-term protection continues to be a top research priority to advise policy makers.”
For the latest vaccine research updates, why not subscribe to our weekly newsletters here? We hope you will also join us at the Congress in Barcelona this month to discuss vaccine questions and explore global health concerns.

by Charlotte Kilpatrick | Oct 11, 2024 | Global Health |
A WHO report in October 2024 suggests that vaccines against 24 pathogens could reduce the number of antibiotics needed by 22% every year. Some of these vaccines are already available but currently underused, but others will need to be developed and brought to market. The report expands on a WHO study from 2023, estimating that some vaccines already in use could avert up to 106,000 deaths caused by AMR each year. Director-General Dr Tedros Adhanom Ghebreyesus highlighted that addressing AMR “starts with preventing infections”, for which vaccines are “among the most powerful tools”.
“Prevention is better than cure and increasing access to existing vaccines and developing new ones for critical diseases, like tuberculosis, is critical to saving lives and turning the tide on AMR.”
The burden of AMR
Antimicrobial resistance (AMR) is the result of bacteria, viruses, fungi, and parasites changing to stop responding to medicines. As medicines become ineffective, infections become harder to treat, which increases the risk of disease spread, severe illness, disability, and death. The report introduces the significant global burden of AMR. In 2019, an estimated 7.7 million deaths were associated with 33 bacterial infections, with almost 5 million of these associated with AMR.
The mortality burden of these drug-resistant infections is “most pronounced” on the African continent, followed by South-East Asia and Eastern Europe. However, community mobility increases the risk of transmission to other continents. AMR has the potential to impose an annual global cost of up US$3.4 trillion by 2030, with the most severe consequences for low- and middle-income countries (LMICs).
A “key driver’ of AMR is the “systematic misuse and overuse” of antimicrobials in healthcare, animal health, and agriculture; the greatest contributor to overall use of antimicrobials is use in animals. The World Organisation for Animal Health (WOAH) estimated that 84,500 tonnes of antimicrobials were used in the animal sector in 2019. However, this is a 13% decrease from 2017. On the other hand, global antibiotic consumption in humans increase by 65% between 2000 and 2015 and is projected to triple (from 2015) by 2030.
One of the major challenges is ensuring equitable access to antimicrobials, particularly in LMICs, where “people are more at risk of dying from a lack of access to appropriate antimicrobials than from resistant infections”. Managing AMR demands both sector-specific and “One Health” approaches. Vaccines can be critical to efforts to lower the burden by reducing the incidence of drug-sensitive and drug-resistant infections, antibiotic use, and opportunities for evolution and transmission of resistant genes and pathogens.
The report
Although we know that vaccines are important aspects of the solution, their specific role in reducing AMR has not been “systematically evaluated and quantified”. Therefore, the latest report evaluates this and provides recommendations for “enhancing the impact of vaccines on AMR”. It covers 44 vaccines targeting 24 pathogens, drawing the characteristics of each vaccine from various sources. Three criteria were considered:
- The AMR-related health burden – measured by the reduction in deaths and DALYs associated with AMR
- Antibiotic use (or antimicrobial use in the case of Mycobacterium tuberculosis)
- The economic burden of AMR, including hospital costs and productivity losses
Highlights from the report
- Vaccines against 16 bacterial pathogens may prevent 510,000 deaths and 28 million DALYs associated with AMR.
- This prediction increases to include an additional 1.2 million deaths and 37 million DALYs when the use of vaccines is expanded to target all populations at risk of infection.
- The non-serotypespecific vaccine against S. pneumoniae, with increased efficacy against lower respiratory tract infections, would have the highest impact on both AMR-associated deaths and DALYs.
- The greatest impact of vaccines on reducing the burden of bacterial AMR in 2019 was in the WHO African Region, averting an estimated 170,000 deaths and 12 million DALYs annually.
- In the WHO South-East Asia Region, vaccines were estimated to have prevented 160,000 deaths and 7.5 million DALYs annually.
- The development and optimal use of vaccines against 23 pathogens could avert up to 2.5 billion defined daily doses a year, which is 22% of the global estimated antibiotic use in humans associated with treating these pathogens.
What’s next?
The authors suggest that the role of vaccines in addressing AMR is “often overlooked” in policy and decision-making processes. They highlight the need for “greater recognition and integration” of vaccines into AMR mitigation strategies and the importance of considering AMR in vaccine decision-making.
“To achieve appropriate inclusion of vaccines in the AMR agenda, the immunisation and AMR communities must strengthen their joint understanding of the evidence and enhance collaboration.”
How do you think that AMR priorities can be incorporated into vaccine development and deployment efforts? Join us for the AMR and bacterial vaccines track at the Congress in Barcelona this month to contribute to these conversations, and don’t forget to subscribe to our weekly newsletters here.

by Charlotte Kilpatrick | Oct 10, 2024 | Global Health |
In October 2024, WHO announced an agreement with the International Monetary Fund (IMF) and the World Bank Group (WBG) on “broad principles for cooperation on pandemic preparedness”. The cooperation is intended to enable scaling up of support to countries to prevent, detect, and respond to public health threats through the IMF’s Resilience and Sustainably Trust (RST), WBG’s financial and technical support, and WHO’s technical expertise and in-country capabilities. The organisations will “leverage their experience to enhance pandemic preparedness”, working on the “synergies and complementarity” of each institution’s in-country analysis and operations.
Principles of coordination
Under the Broad Principles of Coordination:
- WHO and the WBG will continue to lead on health-related development policies and, with other multilateral development banks and The Pandemic Fund, on specific project investments for pandemic preparedness. RST financing will not be earmarked for specific projects.
- Pandemic preparedness policy reform measures supported by RSF arrangements will be informed by existing data, analytics, and operational engagement of WHO, the WBG, and country authorities.
- Pandemic preparedness reforms will build on each institution’s area of expertise. RSF programmes will focus on macro-critical policy reforms within the IMF’s expertise and complement the work carried out by the WBG and WHO to maximise both the financial resources and technical expertise available to countries. RSF Reform measures can include policy actions aimed at enhancing the readiness of finance and health systems to respond effectively to future health emergencies.
The cooperation will enable all three institutions to better serve countries’ efforts on pandemic preparedness.
Working for a safer world
Kristalina Georgieva, Managing Director of the IMF commented that the “stepped-up collaboration” will help the organisations to “complement and leverage each other’s expertise” to support members’ pandemic preparedness and resilience efforts.
“The IMF’s Resilience and Sustainability Trust allows eligible member countries to access affordable, long-term financing to address structural challenges that threaten their macroeconomic stability.”
WHO Director-General Dr Tedros Adhanom Ghebreyesus reflected on the need for “new sources of financing to bolster health systems”, making them “more able to prevent and detect” health threats and to “respond and withstand them when they strike”.
“WHO is proud to be working with the IMF and the World Bank to unlock financing from the Resilience and Sustainability Trust, and support countries to put it to work for a safe world.”
World Bank Group President Ajay Banga suggested that the “deepened collaboration” will focus efforts to help countries prepare for and respond to health threats.
“We must aggressively be planning and preparing for the next global health crisis, so that when the battle comes – and we know it will – we will have the health workforce that can be rapidly deployed in the face of a crisis, laboratories that can quickly ramp up testing, and surge capacity that can be called upon to respond.”
For insights into pandemic preparedness initiatives at the Congress in Barcelona this month get your tickets here, and don’t forget to subscribe to our weekly newsletters here!

by Charlotte Kilpatrick | Oct 10, 2024 | Global Health |
The African Union Development Agency – New Partnership for Africa’s Development (AUDA-NEPAD) announced in October 2024 that Wellcome is granting US$12,301,075 to “support the strengthening and harmonisation of regulatory systems and the operationalisation” of the African Medicines Agency (AMA). The grant will help to drive efforts to “overcome regulatory capacity challenges” to improve access to essential medical products and technologies.
The African Medicines Regulatory Harmonisation (AMRH) initiative has been “pivotal” at creating a “cohesive regulatory environment” for the pharmaceutical sector across Africa since 2009. It focuses on using Regional Economic Communities (RECs) to ensure that African populations have access to high-quality, safe, and effective medical products and health technologies. Wellcome’s grant will be used in alignment with AMRH’s vision of “overcoming barriers” like “limited human and institutional capacity, fragmented regulatory processes, and inconsistent technical standards”.
AMA
AMA’s vision is that “African people have access to essential medical products and technologies”; it hopes to achieve this through the mission: “provide leadership in creating an enabling regulatory environment for pharmaceutical sector development in Africa”. The funding is expected to accelerate efforts to create a “unified and efficient” regulatory framework. The partnership between Wellcome and AUDA-NEPAD is a “major advancement in the pursuit of a robust and harmonised regulatory environment” with positive effects for health outcomes in Africa.
Efficient, connected, fair
Symerre Grey-Johnson Director for Human Capital and Institutional Development at AUDA-NEPAD, stated that the “generous support” from Wellcome is a “crucial endorsement of our mission”.
“With the African Medicines Regulatory Harmonisation (AMRH) intiative laying the groundwork for the African Medicines Agency (AMA), this grant will empower us to address significant regulatory challenges and enhance access to essential medical products for millions of Africans.”
Mr Grey-Johnson believes that the collaboration will “solidify the foundation of the AMA” and ensure a “robust and harmonised” regulatory environment across the continent. Dr Sally Nicholas, Wellcome’s Head of Health Systems and Environment, recognised the AMA’s “crucial role” in creating a “more efficient, connected, and fair regulatory system” in Africa.
“Strengthening regulatory systems is fundamental to improving healthcare outcomes for Africa. By supporting innovative partnerships, initiatives, and solutions to help coordinate effectively operationalise the AMA, we can ensure equitable access to much-needed vaccines, treatments, and interventions for those with the greatest need.”
At the Congress in Barcelona this month we look forward to learning about an AMA pilot with MSD in the Supply and Logistics track; get your tickets to join us there and don’t forget to subscribe to our weekly newsletters here.

by Charlotte Kilpatrick | Oct 9, 2024 | Global Health |
GSK announced in October 2024 that data from the AreSVI-006 (Adult Respiratory Syncytial Virus) Phase III trial of Arexvy indicate that a single dose could offer protection for three RSV seasons. Arexvy is the world’s first RSV vaccine, first approved by the United States FDA in May 2023 for the prevention of lower respiratory tract disease (LRTD) caused by RSV in older adults. The latest trial evaluates the efficacy of a single dose of the recombinant, adjuvanted vaccine against LRTD caused by RSV in adults aged 60 years and older.
RSV is a “common contagious virus” that affects an estimated 64 million people of all ages globally each year. Adults can be at increased risk for RSV disease due to comorbidities, immune compromised status, or advanced age. RSV causes over 465,000 hospitalisations and 33,000 deaths in adults aged 60 and older in high-income countries.
Clinically meaningful efficacy
The results suggest that after a single dose of the vaccine, cumulative efficacy over three full RSV seasons was clinically meaningful at 62.9% against RSV-LRTD and 67.4% against severe RSV-LRTD compared to placebo. In the third season, vaccine efficacy was 48.0% against RSV-LRTD. The data include efficacy against different RSV subtypes, in adults between 70 and 79 years of age, and those with underlying medical conditions.
“Since RSV can exacerbate medical conditions and potentially lead to hospitalisations, cumulative efficacy over three RSV seasons has the potential for significant health impact.”
Another benefit of this protection is that healthcare professionals might have flexibility to administer the vaccine year-round. Over time, revaccination is “expected to be required to maintain an optimal level of protection”. Therefore, GSK will continue to share efficacy and immune response data to inform decisions on immunisation schedules and future revaccination.
GSK’s Chief Scientific Officer Dr Tony Wood is excited by the data, which show that a single dose could “help protect millions of older adults” to “benefit public health”.
“This is the only RSV vaccine with efficacy and safety data available through three full seasons. We will continue to provide data on longer term follow-up to help recommending bodies determine future revaccination schedules.”
We look forward to hearing from senior representatives of GSK, including for perspectives on directing vaccine development for older populations, at the Congress in Barcelona this month. Get your tickets to join us here, and don’t forget to subscribe to our weekly newsletters here!

by Charlotte Kilpatrick | Oct 8, 2024 | Global Health |
A report from Coalition for Life Course Immunisation (CLCI) considers the financial and policy frameworks of various National Immunisation Programmes in Europe with a focus on sustainable financing and informed decision-making. The report addresses access and distribution disparities with “actionable strategies” to ensure everyone receives the vaccinations they need throughout their lives. CLCI describes the analysis as “crucial for stakeholders and policymakers” as a foundation for “advocating for robust, inclusive public health policies” that can be adapting to various healthcare challenges.
Financing and decision-making
The paper presents profiles for 16 European Union Member States: Austria, Belgium, Cyprus, Czechia, Denmark, France, Germany, Greece, Hungary, Italy, Lithuania, Norway, Poland, Romania, Spain, and the Netherlands. These countries are divided into Eastern and Western European nations.
The study finds that the seven Eastern countries had a lower over-65 influenza vaccination coverage rate than the nine Western countries (33% vs 54%). They also spent less of their GDP on healthcare (4.6% vs 6.2%) and less of the healthcare budget on prevention (7.6% vs 10%). Countries with decentralised health systems allocated a higher percentage of their GDP to healthcare and a larger proportion of their healthcare budget to prevention than centralised systems.
7 out of 16 countries reported ringfencing of funds for vaccination and prevention, a common approach for countries that have Ministry of Finance involvement in budgeting. Two countries reported using long-term, multi-year contracts to secure vaccine supply and stabilise financing.
Spotlight on Spain and the Netherlands
As The World Vaccine Congress Europe is taking place in Barcelona this year (2024) and Amsterdam next year (2025) we chose to look more closely at the country profiles of Spain and the Netherlands. The report offers a brief history and an insight into the potential future landscape for both countries:
- Spain – healthcare, including vaccination programmes, has been publicly funded since the establishment of the Spanish National Health System in 1986. Decentralisation in the late 20th century led to “variability” in programme implementation. Spain is “firmly focussed on vaccination as a cost-effective public health measure”. It is increasing investment in public health infrastructure and immunisation coverage will expand to include more diseases and eligible populations. It is also advancing digital transformation through national immunisation registries, enhanced data analytics for decision-making, and digital tools to improve uptake and surveillance.
- The Netherlands – the Dutch National Immunisation Programme (RVP) was established in 1957 to provide free vaccines to all children. This has expanded to include more vaccines. During the COVID-19 pandemic, the budget was allocated “immediately”. Current efforts are underway to “push more proactive allocated budgets to accommodate new vaccines more efficiently”. Demand is driven by an ageing population.
Head-to-head
|
Feature
|
Spain |
The Netherlands
|
|
Health system
|
Decentralised |
Decentralised
|
|
Stakeholders
|
The Public Health Commission of the Ministry of Health, the National Immunisation Technical Advisory Group (NITAG), and regional health authorities |
The Health Council, Dutch National Institute for Public Health and the Environment (RIVM), Ministry of Health
|
|
Introducing a new vaccine
|
New vaccines are evaluated by NITAG before the Public Health Commission recommends updates to the National Immunisation Plan (NIP) and final financing decisions made by regional Ministries of Finances. This means vaccine recommendations can vary between regions. |
New vaccine recommendations from the European Medicines Agency (EMA) go through the Minister of Health and State Secretary, who asks the Health Council to evaluate before funding is considered. After a recommendation from the Health Council, the MoH asks the RIVM to implement the vaccine in the National Immunisation Plan (NIP).
|
|
Primary funding sources
|
Regional governments |
Public funding
|
|
Critical financing challenges
|
High cost of new vaccines, decentralised health system, insufficient political will |
No set budget causes delays, economic pressures, and healthcare budget constraints
|
|
% of GDP spent on healthcare
|
10.4% |
10.2%
|
| % of healthcare budget spent on prevention |
9% |
3.5%
|
Calls to action
The report concludes that the landscape of vaccine financing and decision-making in Europe is “complex”, with “significant variations”. Notably, Ministries of Finance play a key role in healthcare budgeting.
“While some countries have implemented sustainability mechanisms, such as long-term contracts and split investments, budget limitations and political will remain significant barriers to expanding adult vaccination programmes.”
Decentralised health systems demonstrated higher healthcare spending and more investment in prevention; however, this did not necessarily correlate with broader adult vaccine coverage.
The report “advocates for an EU-wide integrated approach to enhance the efficacy of national vaccination strategies for adults” with four specific “calls to action”:
- Strengthen political commitment and sustainable financing
- Increase prevention budgets and foster unity
- Enhance understand and support for vaccination
- Promote comprehensive immunisation programmes
Is your country profile presented in the report? Do you find any of the results surprising, and do you agree with the calls to action? At the Congress in Barcelona this month we look forward to discussing different financing and decision-making approaches with global health experts. Get your tickets to join us for these conversations, and don’t forget to subscribe to our weekly newsletters here.

by Charlotte Kilpatrick | Oct 7, 2024 | Global Health |
Gavi shared the 2023 Annual Progress Report in October 2024, highlighting that more than 1.3 million future deaths were averted in 2023 through Gavi-supported vaccination programmes. The report details progress on strategic goals and reveals that the number of children protected with routine childhood vaccines since 2000 has exceeded 1.1 billion. These milestones also have economic benefits for Gavi-supported countries; the report suggests that this totals US$ 52 billion since 2021.
Chair of the Gavi Board, José Manuel Barroso, emphasised the importance of vaccinating children and vulnerable populations.
“We not only enable millions of people to lead healthier, more fulfilled lives [but we also] contribute to families’ prosperity, to strong and more stable communities, and to economic development that is already translating into countries’ paying more towards their immunisation programmes than ever before.”
Dr Sania Nishtar, Gavi’s CEO, commented that many Gavi countries are “on the front line of climate change, with many vulnerable to economic instability and geopolitical tension”.
“For them to be able to immunise more children, not to mention expand important programmes such as HPV, deserves recognition. Fully funding Gavi for its next five-year period will be crucial in expanding these hard-won gains and helping countries further along the pathway to fully sustaining their own immunisation programmes.”
Indicators and goals
Gavi partners and countries are “on track” to achieve most of the six mission indicators of the 2021-2025 strategic period:
- Under-five mortality rate
- Future deaths averted with Gavi support
- Future DALYs averted
- Reduction in number of zero-dose children
- Unique children immunised through routine immunisation with Gavi support
- Economic benefits generated through Gavi-supported immunisations
The mission is supported by four strategic goals
- Introduce and scale up vaccines
- Strengthen health systems to increase equity in immunisation
- Improve sustainability of immunisation programmes
- Ensure healthy markets for vaccines and related products
Vaccines
National Immunisation Coverage estimates in July 2024 confirmed that Gavi is on track in reaching children with new vaccines but must increase efforts to reach zero-dose and under-immunised children. At the end of 2023, Gavi had helped countries reach more than 1.1 billion children with routine immunisations since 2000. This means that the Investment Opportunity 2021-2025 commitment was achieved two years early. Gavi-supported countries completed a total of 13 routine introductions, taking the total introductions from 2021-2023 to 42.
Coverage of the third dose of diphtheria, tetanus, and pertussis-containing vaccine (DTP3) in 57 lower-income Gavi-supported countries remained “stable” at 80%. Apart from the pentavalent vaccine, Gavi-supported vaccines had higher coverage in 2023 than before the pandemic in 2019. After the opening of the support window for the second dose of inactivated polio vaccine (IPV2) in 2021, overall coverage in Gavi-supported countries increased rapidly to 27% by the end of 2023. The revitalisation of the HPV vaccine programme had “significant” effects: countries fully immunised more than 14 million girls with Gavi support in 2023.
Gavi’s vaccine portfolio has “grown significantly” over time; Gavi now supports vaccines against 20 infectious diseases through 53 product presentations.
Strategy indicators
Breadth of protection: In 2023 the 57 Gavi-supported countries (Gavi57) increased breadth of protection by 3 percentage points to 56%, against an implied target of 60% by 2025.
Coverage: Across the four vaccines included in the Sustainable Development Goal (SDG) indicator 3.b.1, the third dose of pneumococcal conjugate vaccine (PCV3) and the last dose in the schedule of human papillomavirus vaccine (HPVC) were trending higher in 2023 than originally projected. However, coverage of the second dose of measles-containing vaccine (MCV2) was “slightly behind but improving” and coverage of the third dose of DTP3 is “off track”.
Rate of scale up of new vaccines: Coverage of three vaccines (yellow fever: 97%, PCV: 93%, and rotaC: 93%) exceeded the benchmark. RotaC recovered from 2022 supply disruptions. Coverage of MCV2 remained under the 90% relative coverage target.
Introductions: 13 new routine introductions took place in 2023 against a milestone of 21. The cumulative total for introductions in 2021-2023 is 42, just “moderately delayed” against the target of 82 by 2025.
Country prioritisation: Gavi Secretariat considered if funding applications presented the three criteria (disease burden, effectiveness of vaccination, accounting for budget to meet requirements for vaccine procurement and sustain immunisation levels after transition from Gavi support). 93% of applications considered disease burden and increase in budget needed; 76% considered effectiveness of vaccination. 41 applications were reviewed from 2021 to 2023, increasing as countries submitted malaria vaccine applications.
Measles: 75% of children aged under five who were previously unvaccinated against measles received an MCV dose among countries conducting a Gavi-supported preventing MCV campaign.
Timely detection and response: Detection and response challenges, including “suboptimal surveillance” and lack of “robust” preparedness plans and locally available resources “persisted” in 2023. However, 5 out of 28 Gavi-supported outbreak responses with timeliness data met the disease-specific timeliness threshold in 2023. Measles-containing and yellow fever vaccines achieved higher rates of timely response than cholera, Ebola, and meningitis vaccines.
The future
Commenting on the progress presented in the report, UNICEF Executive Director Catherine Russell affirmed that “no child should die from vaccine-preventable diseases”.
“Through Gavi, the Vaccine Alliance we continue to bridge the gap between life-saving vaccines and the children who need them.”
To achieve the goals of the next strategic period, 2026-2030, Gavi needs to meet the funding target of US$9 billion. This will enable the organisation to expand protection against more diseases, ensure that the most vulnerable populations are “not left behind”, and protect the world against disease outbreaks. WHO Director-General Dr Tedros Adhanom Ghebreyesus stated that “vaccines are among the most powerful inventions in history”.
“With continued and increased investment in Gavi, we can harness their power, saving millions of lives in the coming decades.”
How do you think Gavi can continue to make immunisation progress into its next strategic period? What are the key challenges it faces? For more on the biggest vaccine challenges and opportunities to overcome them, join us at the Congress in Barcelona this month or subscribe to our weekly newsletters here.

by Charlotte Kilpatrick | Oct 7, 2024 | Global Health |
WHO Africa reported in October 2024 that the Democratic Republic of the Congo (DRC) has started a vaccination campaign as part of outbreak control efforts against mpox. The vaccination drive has launched in the eastern North Kivu province and will prioritise health workers and frontline responders, contacts of confirmed cases, contacts of those contacts, and other at-risk groups. It will later be implemented in 11 of the most affected health zones in Equateur, North Kivu, Sankiri, South Kivu, Sud-Ubangi, and Tshopo provinces.
Addressing the emergency
The Democratic Republic of the Congo (DRC) has reported more than 30,000 suspected and laboratory-confirmed cases and 990 deaths since the start of 2024. These numbers account for 90% of the cases reported from 15 countries in the African region this year. WHO recommends that vaccination should form part of a “comprehensive response” involving enhanced surveillance, community engagement, and case management. It is working with partners and the national authorities to “scale up and reinforce all the key control measures”.
In preparation for the mpox vaccination campaign, WHO has supported national health authorities in training health workers, enhancing vaccine delivery systems and infrastructure, and community engagement. There are also efforts to “reinforce measures to identify and address” vaccine misinformation and disinformation, responding with increased access to accurate information.
Delivering doses to affected areas
Noting that mpox vaccines are “currently in short supply, especially in Africa”, WHO is encouraging global collaboration to get doses to the people who need them most. In September, WHO prequalified MVA-BN for mpox, which is “expected to facilitate timely and increased access”. It is also working with partners like Gavi and UNICEF to establish a distribution mechanism for donated doses and direct procurements. DRC has received 265,000 doses of MVA-BN, donated by the European Commission’s Health Emergency Preparedness and Response Authority, Gavi, and the United States Government.
WHO Regional Director for Africa, Dr Matshidiso Moeti, expressed gratitude to these partners for their donations.
“As we rally efforts to stop the mpox outbreak, the rollout of the vaccine marks an important step in limiting the spread of the virus and ensuring the safety of families and communities.”
Dr Moeti commented that WHO is “working closely with the national authorities to effectively deliver the vaccines to those who need them most”. Africa CDC also recognised the collaborative effort, which “underscores the collective global commitment” to controlling the outbreak in Africa. H.E. Dr Jean Kaseya, Africa CDC Director General, commended the DRC’s “swift action” in launching the campaign, which “showcases the strength of its public health leadership”.
“By prioritising vulnerable populations, including frontline health workers and those most at risk, the country is taking critical steps to contain the outbreak. Africa CDC remains committed to working closely with the DRC to ensure vaccines reach those who need them the most, while also working to strengthen health systems to prevent future outbreaks. Our top priority is to secure safe and effective vaccines for children in the next phase of vaccination.”
Mpox vaccination will be a key area of high-level discussions at the Congress in Washington next April, including on a keynote panel that will consider the “role of vaccines in a changing world”. Get your tickets to join us for these conversations, and don’t forget to subscribe to weekly vaccine updates here.

by Charlotte Kilpatrick | Oct 7, 2024 | Global Health |
A week after the declaration of a Marburg outbreak in Rwanda in September 2024, Sabin Vaccine Institute announced that it is providing doses of its investigational Marburg vaccine to support the outbreak response. An initial shipment of approximately 700 doses will be used in a trial involving frontline workers, including healthcare professionals, who have been the “hardest hit” by this outbreak. Sabin and the Rwanda Biomedical Centre have entered a clinical trial agreement for a Phase II rapid response open label study, which will be conducted at six trial sites in Rwanda. Sabin also plans to supply additional vaccines, pending a request from Rwandan officials and authorisation from BARDA.
Responding to the outbreak
The outbreak was declared on 27th September 2024, and by 6th October it had caused 12 deaths. Many cases are among health workers in two facilities in Kigali, but there are more cases spread across other districts. Sabin has been “working directly” with Rwandan officials and partners to support the response. There are no licensed vaccines or treatments for Marburg, but Sabin’s single-dose vaccine is in Phase II trials in Uganda and Kenya, with no safety concerns reported to date. The vaccine is based on the ChAd3 platform and results from Phase I clinical trials and nonclinical studies suggest that it is safe and elicits “rapid” and “robust” immune responses.
Commenting on the support from Sabin, Rwanda’s Minister of Health Dr Sabin Nsanzimana reflected that “in emergency situations, the success of clinical trials relies on quick, strategic global partnerships” that combine “expertise, resources, and innovation”.
“Today, a week after this Marburg outbreak was first confirmed, we are receiving doses of the Sabin Vaccine Institute’s Marburg vaccine candidate to protect our health workers and other high-risk groups, and also advance scientific tools which will ensure this virus can be effectively controlled now and in the future.”
Lightning speed
Sabin’s Chief Executive Officer Amy Finan described the team’s “lightning speed” in responding to the Rwandan government’s request for assistance, preparing shipments, finalising protocols, and securing regulatory and legal approvals.
“This swift emergency response demonstrates that a dedicated, collaborative group of individuals and organisations can achieve remarkable results when united by a common cause: to contain a lethal disease outbreak and prevent further loss of life.”
ReiThera, Sabin’s manufacturing partner, has produced the drug substance and filled and finished doses for shipment. CEO Stefano Colloca stated that the ReiThera team believes in the “transformative power of global collaboration to advance science and create lasting impact”.
“Our partnership with Sabin highlights our shared commitment to developing a life-saving vaccine against Marburg disease with a mutual goal: to save lives and ensure that even the most vulnerable communities around the world have access to vital and equitable protection.”
Sabin’s vaccine progress
Sabin plans to launch a Phase II trial of the Marburg candidate in the United States next year, as it looks forward to interim results from the trial in Uganda and Kenya. The development programme is supported by BARDA, which has committed $235 million for advancing vaccine research and development against Sudan ebolavirus and Marburg virus diseases.
To join discussions about safety and effectiveness evaluations of vaccines deployed in emergency situations, get your tickets to the Congress in Barcelona this month. Don’t forget to subscribe to our weekly newsletters for vaccine updates.

by Charlotte Kilpatrick | Oct 4, 2024 | Global Health |
The University of Oxford announced in October 2024 that scientists working on ‘OvarianVax’ a vaccine to encourage the immune system to “recognise and attack” the earliest stages of ovarian cancer, have secured funding from Cancer Research UK. The team will receive up to £600,000 over the next three years to support research from establishing targets to possible clinical trials. Although getting a vaccine to the point where it is “widely available to women at risk of ovarian cancer” is “many years” away, the funding is an “exciting step” towards preventing ovarian cancer at an early stage, rather than treating it after it has taken hold.
Ovarian cancer
Ovarian cancer is the 6th most common cancer in women, causing around 7,500 new cases every year in the UK. There is currently no screening programme for the disease, and some women with are at higher risk with inherited copies of altered genes. Compared to women without gene alterations, women with altered BRCA1 genes face a higher risk by up to 65%, and women with altered BRCA2 genes face a higher risk by up to 35%.
Women with these alterations are recommended to have their ovaries removed by the age of 35, which has implications for having children and brings on early menopause. Many cases of ovarian cancer are only identified at a late stage. Professor Ahmed Ahmed is the Director of the Ovarian Cancer Cell Laboratory, MRC Weatherall Institute of Molecular Medicine at the University of Oxford, and lead for the OvarianVax project and comments that “we need better strategies to prevent ovarian cancer”.
“Currently women with BRCA1/2 mutations, who are at very high risk, are offered surgery which prevents cancer but robs them of the chance to have children afterwards.”
However, a possible “solution” could be on the horizon with the OvarianVax project, focussed on women at high risk but with potential to expand if trials are successful.
“Thanks to this funding, our research can take a big step forward towards a viable vaccine for ovarian cancer.”
Vaccine development
The researchers will identify the proteins on the surface of early-stage ovarian cancer cells that are most strongly recognised by the immune system and work out how effectively the vaccine kills organoids, “mini-models” of ovarian cancer. If this proves successful, they will move forward to clinical trials in the hope that one day women could be offered the vaccine to prevent ovarian cancer.
“Teaching the immune system to recognise the very early signs of cancer is a tough challenge. But we now have highly sophisticated tools which give us real insights into how the immune system recognises ovarian cancer.”
Professor Ahmed’s team has already found that immune cells from patients with ovarian cancer can “remember” the tumour. They will use this discovery to train the immune system to recognise over 100 proteins on the surface of ovarian cancer, known as tumour-associated antigens. The research will uncover which antigens trigger the immune system to recognise and kills cells that are becoming ovarian cancer, using tissue samples from the ovaries and fallopian tubes of people with ovarian cancer to recreate the early stages of disease.
The team will also work with patient and public representatives to understand who would be willing to take the vaccine, who would receive the most benefit from it, how it could be administered, and how to ensure it is taken up by as many eligible women as possible if it is successful in clinical trials.
Prevention research strategy
This is one of several projects that Cancer Research UK is funding within its prevention research strategy, which seeks to use discoveries from the lab to find more precise ways to prevent cancer. Cancer Research UK’s Chief Executive, Michelle Mitchell, described these projects as “a really important step forward into an exciting future, where cancer is much more preventable”. The funding should “power crucial discoveries” that can be used to “realise our ambitions to improve ovarian cancer survival”.
“OvarianVax builds on the exciting developments in vaccine technology during the pandemic. This is one of the many projects which we hope will give women longer, better lives, free from the fear of cancer.”
For more on using the latest lab discoveries to improve patient outcomes with vaccines, get your tickets to the Congress in Barcelona this month, and don’t forget to subscribe to our weekly newsletters here.

by Charlotte Kilpatrick | Oct 3, 2024 | Global Health |
WHO announced in October 2024 that it is launching the Global Strategic Preparedness, Readiness, and Response Plan (SPRP) to tackle dengue and other Aedes-borne arboviruses. The Plan is intended to reduce the burden of disease, suffering, and deaths from dengue and other Aedes-borne arboviral diseases, like Zika and chikungunya, by “fostering a global coordinated response”. It presents priority actions to control transmission and offers recommendations to affected countries across various sectors. With five “key components”, the Plan is to be implemented over one year until September 2025, demanding US$ 55 million.
“The SPRP is a call to action for all stakeholders – from government agencies and health-care providers to communities and individuals – to join forces in the fight against dengue and other Aedes-borne arboviruses, through innovation, new technologies, and improved vector control strategies.”
Turning the tide
In the foreword by WHO Director-General Dr Tedros Adhanom Ghebreyesus we learn that dengue has “afflicted humanity for centuries, and possibly longer”; the first report of a clinically compatible case is recorded in a Chinese medical encyclopaedia in 992. From a much more contemporary perspective, dengue has spread “rapidly” in the past 20 years, enabled by “increased global travel and the effects of climate change”. Between 2000 and 2019, WHO documented a “tenfold surge” in reported cases, to 5.2 million. Since then, the surge has continued; over 12.3 million cases were reported by the end of August 2024.
The global prevalence and effects of arboviruses like dengue are a “significant threat to public health”, particularly in tropical areas where they are endemic. Addressing this threat demands a “concerted, strategic, and informed response”, which the Director-General hopes to achieve with the SPRP, a “comprehensive plan” to outline ways of controlling Aedes-borne arbovirus transmission in affected countries.
“Our multifaceted approach emphasises integrated surveillance, laboratory diagnosis, vector control, community engagement, clinical management, and research and development.”
This approach should reduce the burden of disease, save lives, and minimise the socioeconomic consequences of these diseases. Furthermore, the Plan includes measures for “safe programming” to ensure interventions are “secure and do not exacerbate the risk” for those who are already vulnerable to disease or those involved in responding to the crisis. Dr Tedros states that prevention and control is a “shared responsibility”.
“Together, we can turn the tide against this disease, protect vulnerable populations, and pave the way for a healthier future.”
Understanding the threat
Dengue is a challenge across all of WHO’s regions, endemic in more than 100 countries. Various factors, such as unplanned urbanisation and the effects of climate change, fuel the spread of dengue and other Aedes-borne arboviruses, such as Zika and chikungunya, putting more than four billion people at risk. The growing threat must be addressed with a “robust and dynamic strategy” that accounts for the current global epidemiological landscape. This is complicated by the “still developing” global surveillance system.
Transmission drivers like the effects of climate change and population growth can explain the increase of these infections in some areas, but they also point to the need for a multisectoral approach to prevent and respond to outbreaks.
The Plan
The Plan is intended to “reduce the burden of disease and deaths from dengue and other Aedes-borne arbovirus diseases in all affected WHO regions”. The strategic objective is “to accelerate progress in preventing and controlling dengue and other Aedes-borne arboviral disease outbreaks worldwide”, with the following specific objectives:
- Strengthen global multisectoral coordination and collaboration among stakeholders and partners in preparedness, response, and resilience to dengue and other Aedes-borne arbovirus diseases
- Enhance the capacity of Member States in early detection, reporting, confirmation, and response to outbreaks of dengue and other Aedes-borne arboviruses
- Strengthen the capacity of Member States to implement effective vaccination and integrated vector management strategies for mitigating the transmission of dengue and other Aedes-borne arboviruses
The SPRP combines strategic interventions tailored to local contexts and leverages inter-stakeholder synergies to “confront the challenges” posed by these diseases and move closer to controlling them. The following “interconnected pillars” are included in the multidisciplinary approach:
- Leadership, coordination, planning, monitoring, and prevention of sexual misconduct
- Risk communication and community engagement (RCCE) and infodemic management
- Surveillance, case investigation, and contact tracing
- Travel, trade, and points of entry surveillance and control
- Laboratory and diagnostics
- Integrated vector management and WASH & IPC
- Clinical management and therapeutics
- Operational support and logistics
- Essential health services and systems
- Vaccination
- Research, innovation, and evidence
The 5Cs
The SPRP aligns with WHO’s 2023 Framework for Health Emergency Prevention, Preparedness, Response, and Resilience (HEPR) with a focus on five “core health emergency components”:
- Collaborative surveillance
- Strong national integrated disease, threat, and vulnerability surveillance,
- Effective diagnostics and laboratory capacity for pathogen and genomic surveillance
- Collaborative approaches for event detection, risk assessment, and response monitoring
- Community protection
- Community engagement, risk communication, and infodemic management
- Population and environmental public health interventions
- Multisectoral action for social and economic protection
- Access to countermeasures
- Fast tracked research and development
- Scalable manufacturing platforms
- Coordinated supply chains and emergency
- Emergency coordination
- Strengthened workforce capacity for health emergencies
- Strengthening health emergency preparedness, readiness, and resilience
- Health emergency alert and response coordination
- Safe and scalable care
- Scalable clinical care during emergencies
- Protection of health workers and patients
- Maintenance of essential health services
How do you think the SPRP can be effectively translated into specific contexts and implemented sustainably?
For insights into vaccination efforts for diseases that are being exacerbated by the effects of climate change, get your tickets to the Congress in Barcelona this month, or subscribe to our weekly newsletters here.